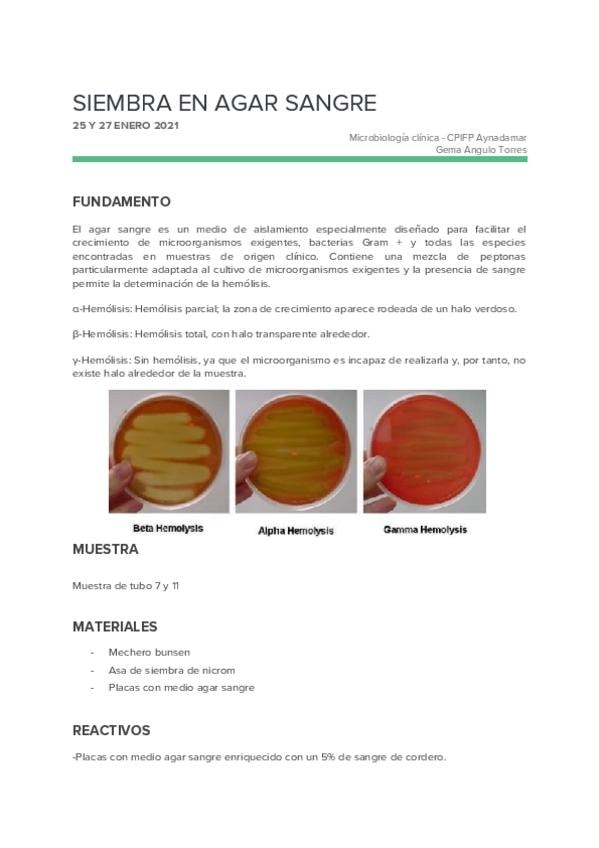

10.pdf
3 páginas

15.oxidasa.docx

18.RESIEMBRA.docx

17.-OF.docx

11.Siembra-en-medio-CLED.docx

16.ONPG.docx

13.-Diluciones-decimales-seriadas.docx

12.pdf
4 páginas

14.-catalasa.docx
26.Agar-sangre.docx

19.Indol.docx

22.Citrato.docx

20.Rojo-de-metilo.docx

24.Nitratasa.docx

25.-Manitol-salado.docx

23.-Agar-hierro-de-kligler.docx

21.-VP.docx

29.Antibiograma.docx

30.Enterotube.docx

27.-bilis-esculina.docx

28.DNasa.docx

32.-API-20-NE.docx

31.API-20E.docx
content_copy